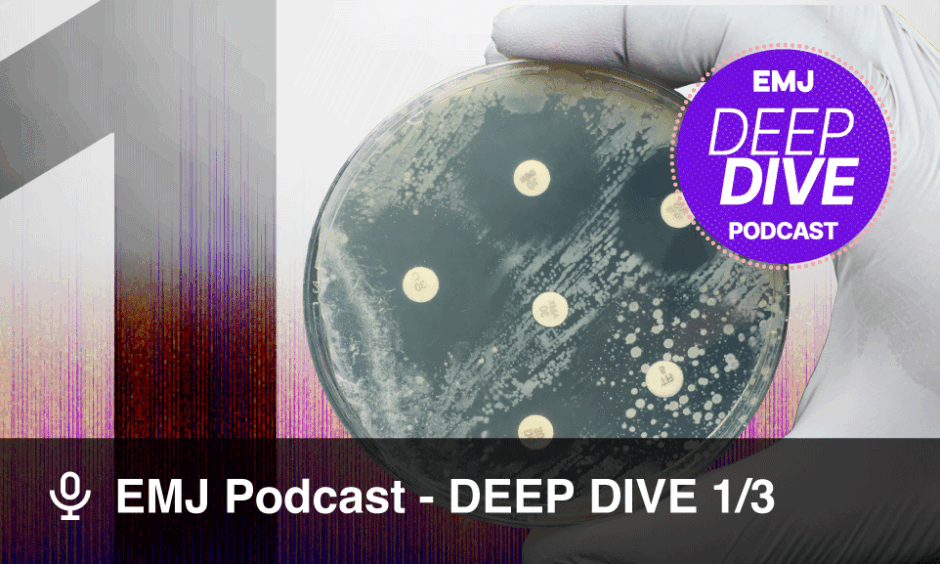

EMJ Podcast | Quickfire & Deep Dive
What does antimicrobial resistance (AMR) look like at the bedside? In the second episode of our special AMR series, The Silent Pandemic, Matteo Bassetti sits down with host Catherine Glass to explore how AMR is shaping hospital care, the real-world challenges of antibiotic stewardship, and the policies and preparedness strategies needed to manage resistant infections today and tomorrow.
Speaker Bio:
 Matteo Bassetti is Head of the Infectious Diseases Clinic at Policlinico San Martino University Hospital, Genoa; and Full Professor of Infectious Diseases at the University of Genoa, Italy. A European leader in antimicrobial resistance, he focuses on severe infections, patients who are critically ill and immunocompromised, and hospital stewardship. He serves as President of the Italian Society of Anti-infective Therapy (SITA) and advises national and international committees on antimicrobial resistance policy and preparedness.
Matteo Bassetti is Head of the Infectious Diseases Clinic at Policlinico San Martino University Hospital, Genoa; and Full Professor of Infectious Diseases at the University of Genoa, Italy. A European leader in antimicrobial resistance, he focuses on severe infections, patients who are critically ill and immunocompromised, and hospital stewardship. He serves as President of the Italian Society of Anti-infective Therapy (SITA) and advises national and international committees on antimicrobial resistance policy and preparedness.